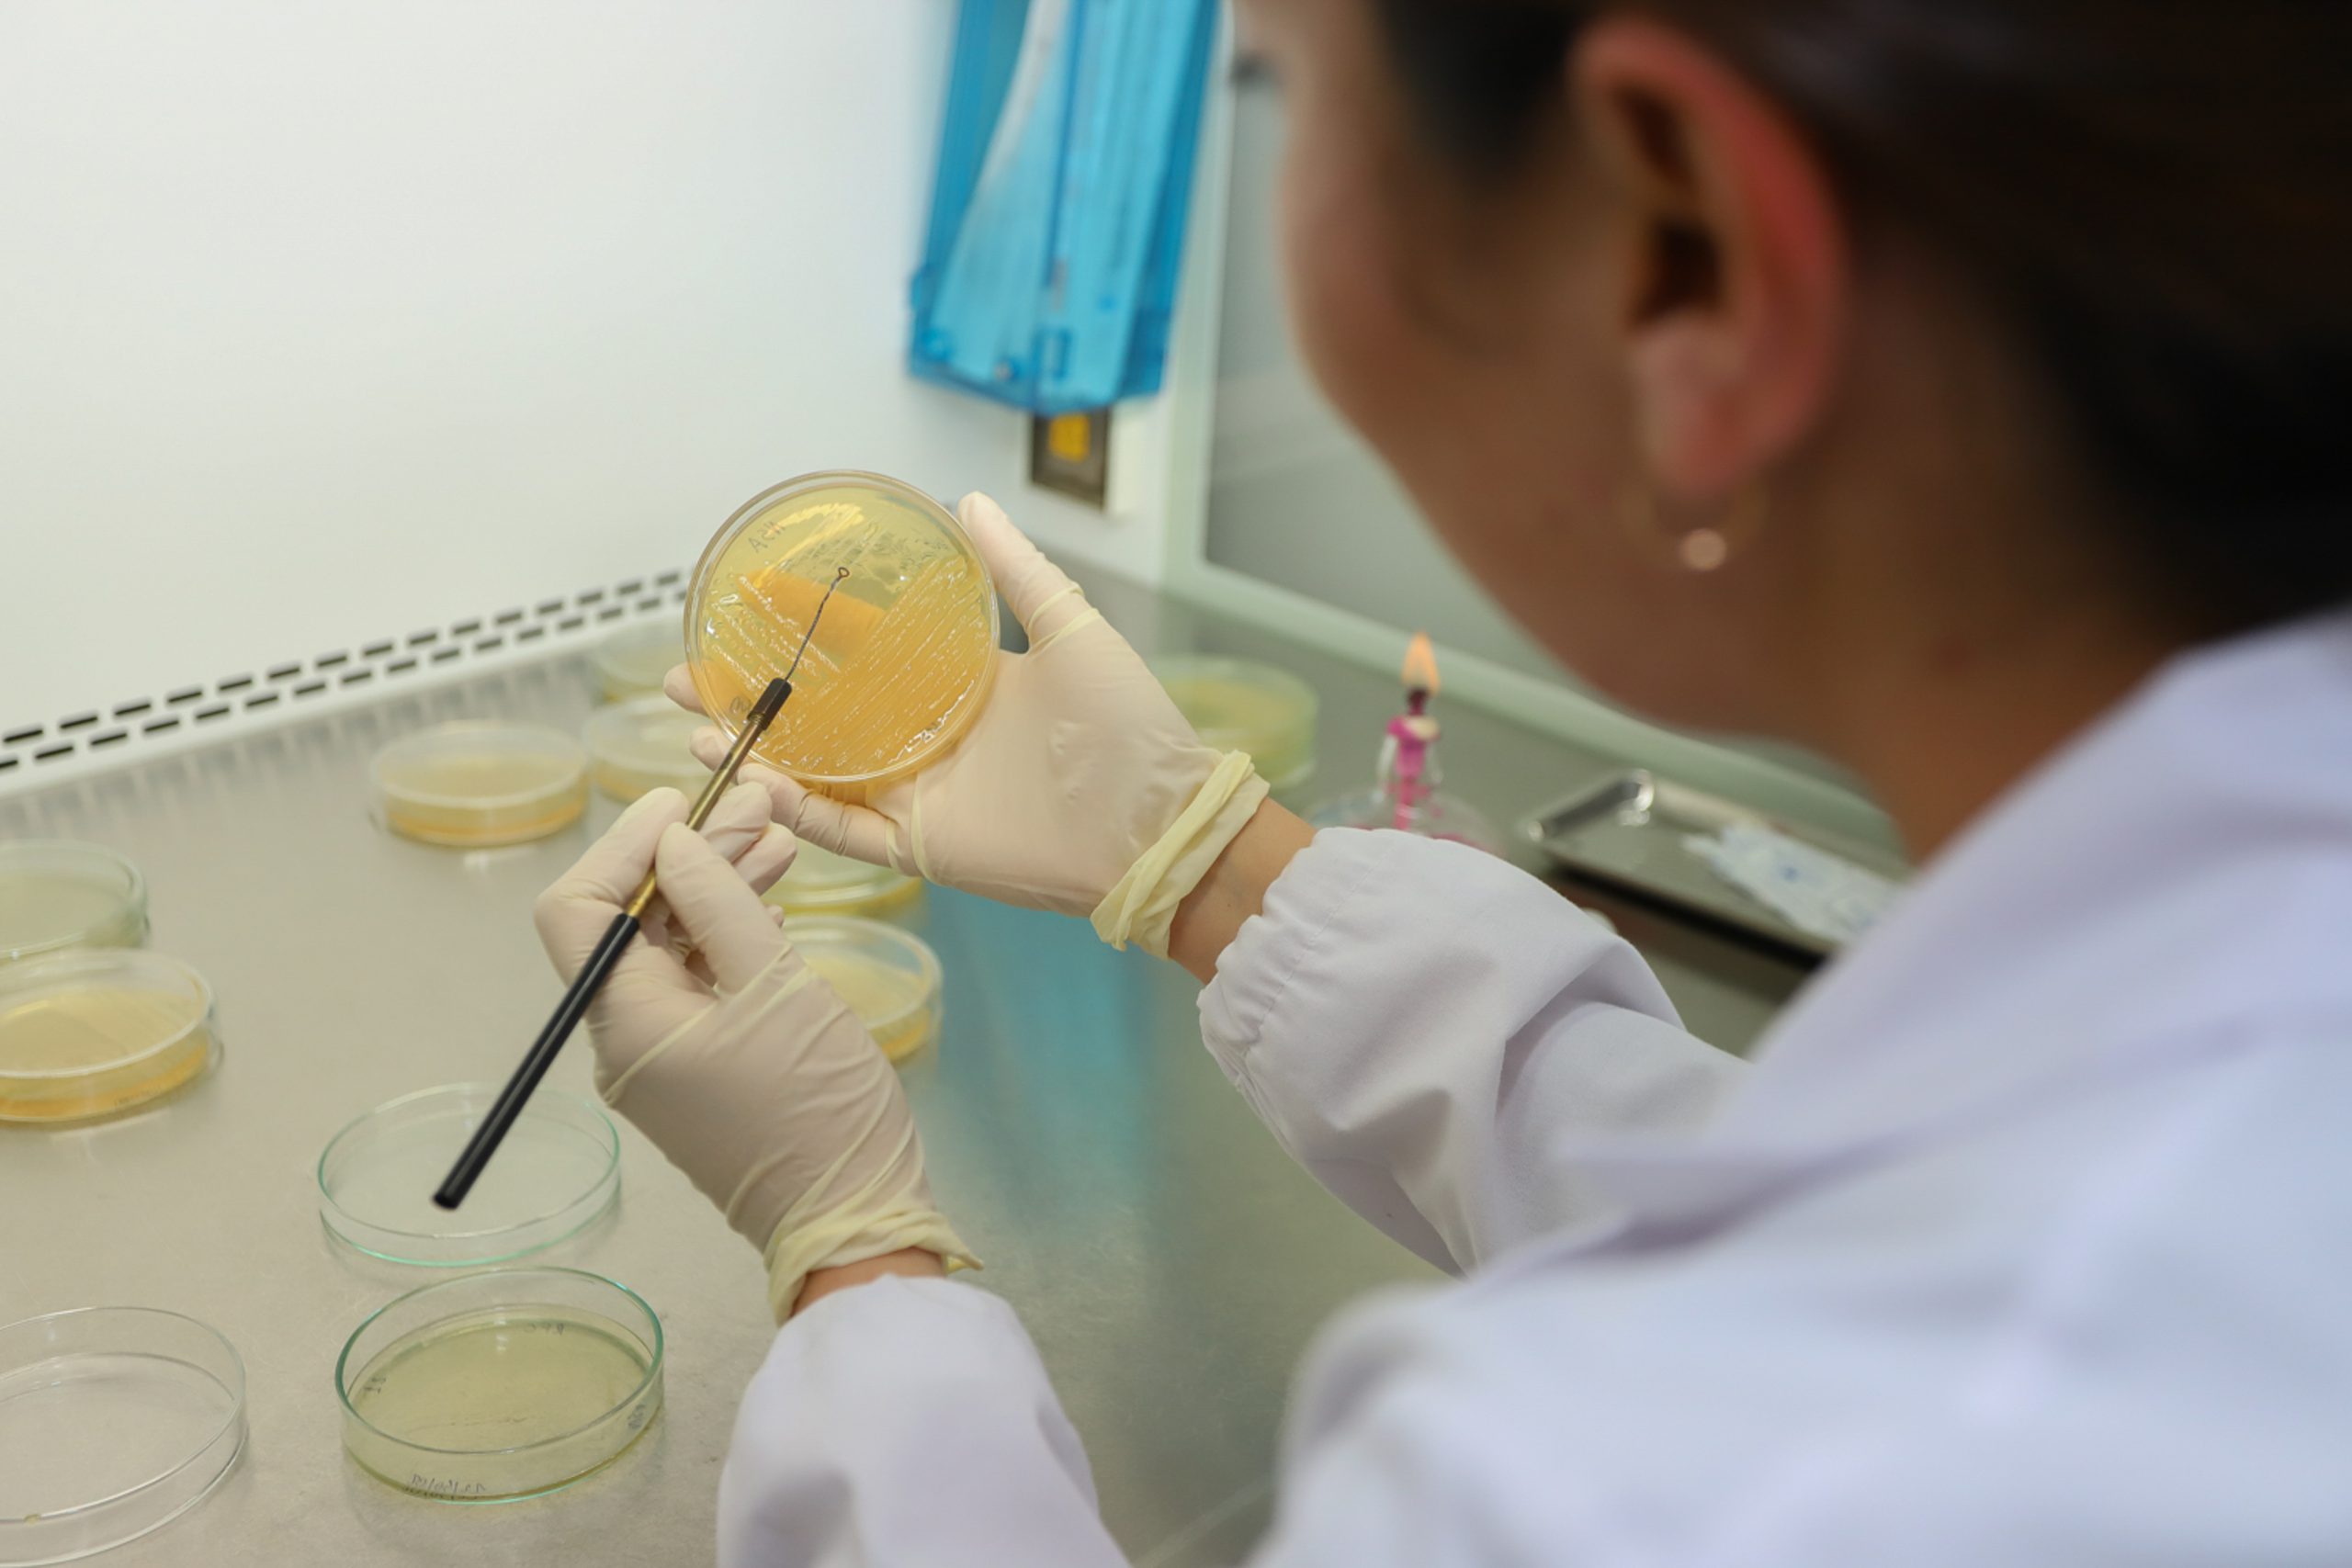

La iniciativa busca que las y los alumnos de la Casa de Estudios vivan la experiencia, bajo su formación académica, de participar -durante cuatro semanas- en una investigación que esté siendo desarrollada por un/a investigador/a de cualquiera de los cinco institutos, de manera de adquirir competencias en este ámbito.
Con la intención de acercar a las y los estudiantes a la investigación, la Vicerrectoría de Investigación, Postgrado y Vinculación UOH, a través de la Dirección de Investigación, desarrollaron el Fondo de Investigación para Estudiantes de Pregrado de la Universidad Estatal de O’Higgins (UOH).
La iniciativa busca que los/as estudiantes de Pregrado de la casa de estudios tengan la experiencia, en el marco de su formación académica, de participar -durante cuatro semanas- en una investigación que esté siendo desarrollada por un/a investigador/a de cualquiera de los cinco institutos de la universidad, de manera de adquirir competencias en este ámbito.
El director de Investigación, Patricio Velasco, sostuvo que este tipo de instancias son parte de las líneas de trabajo que está promoviendo actualmente la Universidad. “Queremos que los/las estudiantes de la UOH puedan vincularse tempranamente a la investigación, que tengan la experiencia de participar en el desarrollo de proyectos que están llevando a cabo nuestros/as investigadores/as, por lo que hemos diseñado y puesto en marcha esta primera versión del Fondo, correspondiente al verano 2023. Está previsto convocar dos veces al año cuando los/as estudiantes estén de vacaciones”, explicó.
El requisito fundamental para participar de esta instancia es haber cursado al menos dos semestres y tener la condición de estudiante regular. Luego, debe seleccionar alguna de las líneas de investigación propuestas por los/las investigadores/as guía y acordar directamente con él o ella la forma en que se llevará a cabo el trabajo.
“Hemos solicitado a los/as académicos/as que propongan una o dos líneas de investigación en la cual, los/as estudiantes puedan participar. Hemos tenido una recepción muy positiva por parte de ellos/as”, agregó Patricio Velasco
Una vez finalizadas las cuatro semanas, el/la estudiante debe presentar un informe, también suscrito por el/la investigador/a guía, que dé cuenta de lo realizado durante el desarrollo de su actividad de investigación. Los/las estudiantes que participen de esta iniciativa obtendrán, además de un ingreso, un certificado que acredite la labor realizada y la posibilidad de participar en un congreso. “Este programa contempla la organización de un congreso anual donde los/as estudiantes puedan presentar la labor de investigación realizada”, concluyó el director.